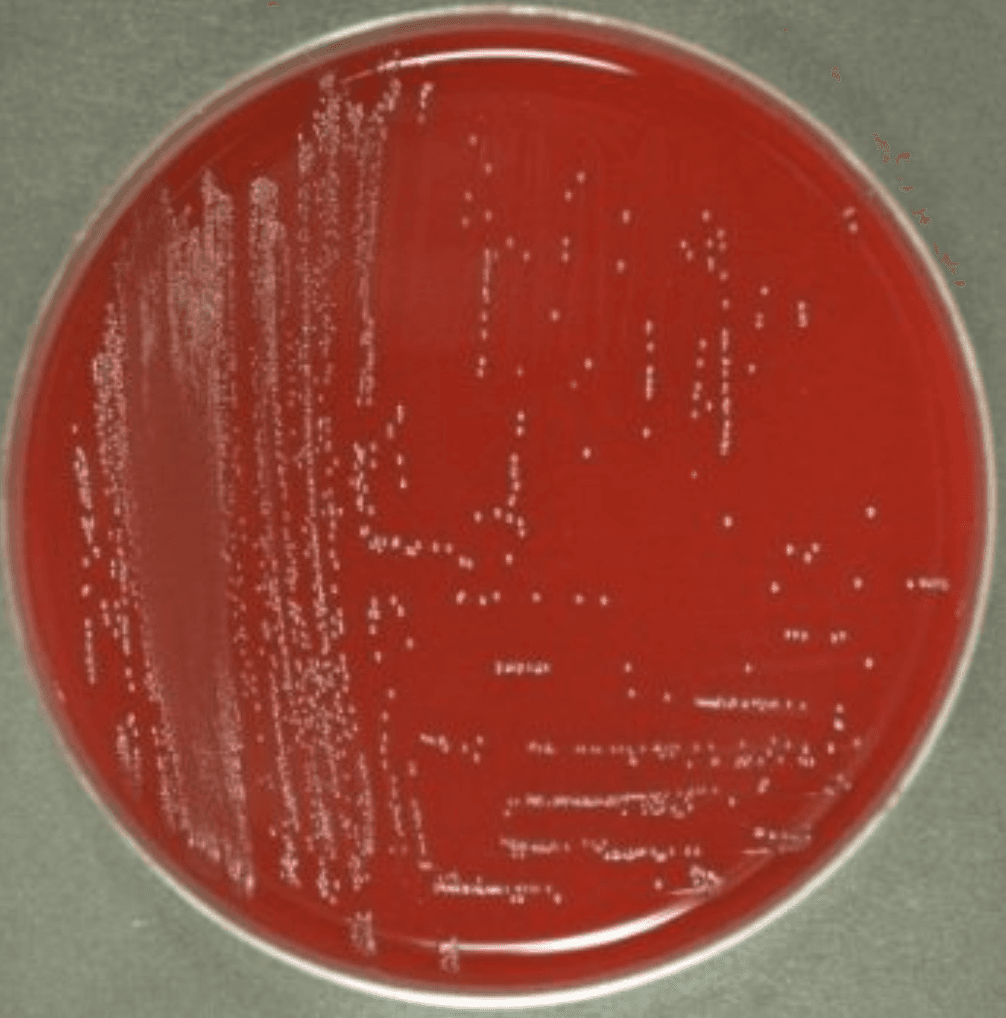
Culture plate from a positive clinical specimen showing small gray colonies

When Ceftriaxone Fails
Clinical Vignette
A 58-year-old man with alcohol-associated cirrhosis, refractory ascites, and prior spontaneous bacterial peritonitis is admitted after an esophageal variceal hemorrhage. Band ligation achieves hemostasis, and he receives intravenous ceftriaxone for post-bleeding prophylaxis. On hospital day 4 he develops fever, abdominal pain, hypotension, and worsening ascites.
He has had multiple recent hospitalizations and takes chronic ciprofloxacin prophylaxis. Diagnostic paracentesis reveals infected ascites, and blood and ascitic fluid cultures grow Enterococcus faecium with ampicillin resistance, vancomycin resistance, retained linezolid susceptibility, daptomycin susceptible-dose-dependent status, and a detected vanA determinant. A central venous catheter is removed, but repeat blood cultures remain positive 24 hours later, and transthoracic echocardiography is technically limited. The primary team asks how the vanA result should be interpreted and how persistent vancomycin-resistant E. faecium bacteremia should change management.
Initial culture plate from the current admission. Final organism identification is established by laboratory testing, not by plate appearance alone.
Question 1
Which of the following best explains why species-level identification of this bloodstream isolate as Enterococcus faecium has immediate therapeutic significance?
Select one option to submit your answer and view live poll results.
Question 2
Which of the following is the most accurate interpretation of the vanA determinant detected in this Enterococcus faecium isolate?
Select one option to submit your answer and view live poll results.
Question 3
Blood cultures remain positive 24 hours after catheter removal. Which of the following is the most appropriate next step in management?
Select one option to submit your answer and view live poll results.
References
Arias CA, Murray BE. The rise of the Enterococcus: beyond vancomycin resistance. Nat Rev Microbiol. 2012;10(4):266-278.
Miller WR, Munita JM, Arias CA. Mechanisms of antibiotic resistance in enterococci. Expert Rev Anti Infect Ther. 2014;12(10):1221-1236.
Rosselli Del Turco E, Bartoletti M, Dahl A, Cervera C, Pericas JM. How do I manage a patient with enterococcal bacteraemia? Clin Microbiol Infect. 2021;27(3):364-371.
Turnidge J, Kahlmeter G, Canton R, MacGowan A, Giske CG. Daptomycin in the treatment of enterococcal bloodstream infections and endocarditis: a EUCAST position paper. Clin Microbiol Infect. 2020;26(8):1039-1043.
Kitchen P, Schutte SL, Tergast TL, et al. Altered Pathogen Spectrum of Spontaneous Bacterial Peritonitis in Patients Treated With Proton Pump Inhibitors. Aliment Pharmacol Ther. 2026 Feb 17. Online ahead of print.